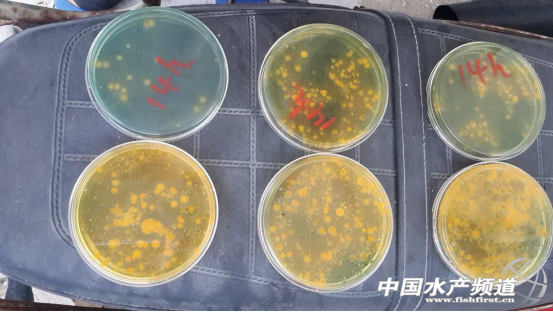
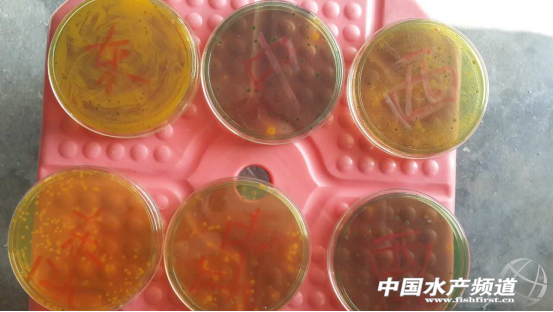

日志
水體微生物平衡控制設備(水調器)/水處理設備
|
現在水產養殖的人比較多,但是能盈利的卻很少。經調查反饋,目前由于水質污染日趨嚴重,養殖環境堪憂!導致養殖成功率僅在10-20%,能盈利的還不到10%;同時由于產品的耐藥性及傳統飼養方式,使成品的品質大幅下降,有的人還面臨低價收購和外埠水產的沖擊。而現在有一種物理殺菌的方法就能解決這個問題了。這是一款水體生態環境平衡控制設備,一個“水調器”=溶氧設備+過濾設備+殺菌設備
其優點:
獨有的核心技術減少繁育、養殖過程中抗生素的使用和生物體耐藥性的發生,全面提升產品的品質,提高存活率
有效平衡養殖環境生態結構,提高整個水體的利用率,逐步使水體環境趨于自然健康狀態;
契合產業中各種成熟養殖方案,還原在產業初期,良好生態環境下簡單易行的水產品養殖模式,實現養殖標準化。
產品功能:
首次開機8小時后,就能降低宏觀水體中10-100倍的微生物菌落總數,接近於自然常態指數;
能夠持續控制水體微生物生態環境結構,保證水體營養豐度和優良水質,提高養殖的水產品存活率及質量,實現更高收益。
“水調器”VS 傳統技術 | |
“水調器”技術 | 傳統技術 |
√持續維持養殖環境在自然常態,改善水質的同時提高使用率 √減少泛用抗生素的控制手段 √契合成熟養殖方案,根源上促進產業健康,加快水產品成熟速度,縮短養殖周期,提升水產品質量,實現品牌與利潤的飛躍 √一次性投入,可持續使用3年,壽命期內僅需低成本維護
| √需根據水質狀況頻繁更換養殖用水,加劇水體惡性循環污染 √養殖過度依賴抗生素 √水產品逐代品質下降,產業危機加深,養殖過程即使用藥,魚蝦健康程度仍無法掌握,養殖成功率低 √養殖成本與收益不成正比,養殖戶面臨巨大經濟風險
|
“水調器”技術帶來水產業的變化 | |
未來的養殖 | 現在的養殖 |
養殖4.0模式 √促進高品質的水產業騰飛 √高新技術使養殖變成簡易的標準化,實現高利潤增長點 √個性化智造,滿足更多水產品種類的養殖,符合行業未來消費趨勢
| 養殖過去式 √加劇中低品質的水產業競爭 √眾多養殖方案只能短期局限解決部分養殖問題,風險爆發不可控 √作坊式小規模養殖,品種空間漸趨狹小,同質化競爭變成常態,盈利需要運氣
|
水調器實驗
一、水調器的使用體驗
1、吳陽王潔平養殖場的使用效果:1畝蝦塘1臺水調器持繼使用12小時,結果:副溶血性弧菌減少約30-40%,中間死角位效果較差。繼續使用20小時,結果,和之前無明顯變化。初步估計:1臺水調器沒有辦法完全處理完1畝水體。
2、第二次實驗,再增加一臺水調器,經過12小時后效果變化非常明顯,副溶血性弧菌基本達到完全殺滅效果,只的中間與西面死角位存在一點點殘留,已經達到安全養殖指標。
3、湖光許總養殖場的使用對比:實驗塘和對比塘20天沒有換水,實驗塘與對比塘的水質有明顯的差異,證明水調器能有效保持水質穩定,各種生物制劑使用效果明顯提升。
二、養殖中各種弧菌的危害性
對蝦養殖遭受了嚴重病害,尤其是對蝦“偷死”情況嚴重。雖然種質退化、天氣惡劣、養殖密度高、養殖水質惡化等難辭其咎,但從整個疫情上來看,對蝦養殖中弧菌貫徹始終,可謂“魅影重重”。
1、弧菌及弧菌病
弧菌是海洋中常見的細菌類群之一,該類細菌具很強的適應性和抗逆性,因此成為海水環境的優勢種群,尤以溶藻弧菌、副溶血弧菌、鰻弧菌等占優勢。隨著養殖迅速發展,養殖水域生態變化,弧菌病已經成為海水養殖動物主要的細菌性病害之一。且具有流行廣、發病率高、危害大、死亡率高等特點,給魚、蝦、蟹及貝類等海水動物的養殖造成了巨大的影響。溶藻弧苗是中國對蝦黑鰓、褐斑綜合癥的病原菌。副溶血弧菌是一種嗜鹽菌,主要存在于近海岸的海水、海底沉積物以及魚類、貝類等海產品中。其流行廣,危害較大,發病率、死亡率也高,廣泛存在于海水中,但夏季海水中的含量比冬季要高。
2、對蝦弧菌病癥狀
弧菌病是對蝦養殖中最為常見的、危害較大的一類疾病,其主要癥狀一般為:紅腿、黃鰓、斷須、額劍和尾部潰爛;對外界反應遲鈍。部分蝦體發黑和肌肉白濁;自患病對蝦體內抽取的血淋巴凝固緩慢,顏色也由正常的淡藍色變為微紅色。解剖發現肝胰腺腫大、變紅;中腸內無食物殘留。近年來所發生的對蝦“偷死病”是由弧菌屬的副溶血性弧菌引起,但其所引起的弧菌病的特點:對蝦少量進食或不進食,腸胃空無食物,肝胰臟明顯萎縮,蝦體不紅(變得更透明)。染病對蝦很少在水面游動,常常趴在池邊,活力較弱,在土池中有扒沙泥現象,而且死亡一般發生在池底。
三、優勢
1、殺菌(針對:副溶血性弧菌、大腸桿菌、金黃色葡萄球菌、銅綠假單胞菌、白色念球菌且有較好的殺滅效果)
注:目前在對蝦養殖過程中由于弧菌引發的偷死病是養殖戶面臨的老大難問題,市面上還沒有特效藥針對偷死病,現在的處理方法只能是消毒與氧化,效果不理想,容易反彈。
2、能有效保持水質穩定(各種生物制劑使用效果明顯提升)
3、增氧
“水調器”產品結構圖(以SUP/3系列為例)
注:“水調器”配置要求:建議每畝配1臺,極限為1.5畝配1臺;